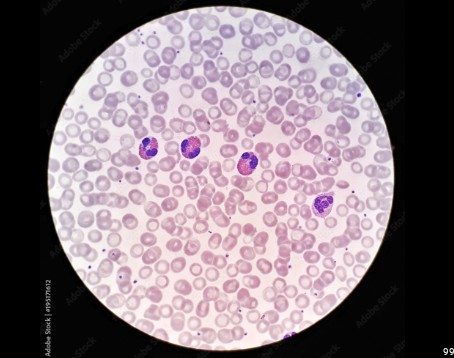
knowt flashcard image
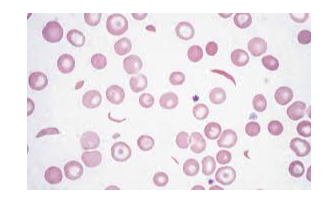
knowt flashcard image

Connective Tissue Microscope
1/25
There's no tags or description
Looks like no tags are added yet.
Name | Mastery | Learn | Test | Matching | Spaced |
|---|
No study sessions yet.
26 Terms
Simple Squamous Epithelium- Epithelial

Simple Cubodial Epithelium-Epithelial

Simple Columnar Epithelium-Epithelial

Simple Ciliated Columnar-Epithelial

Frog Ciliated Epithelium- Epithelial

Pseudostratified Ciliated Columnar Epithelium-Epithelial

Transitional Epithelium-Epithelial

Straitifed Squamous Epithelium-Epithelial

Human Skin-Pigmented Epithelium-Epithelial

Frog Skin Epithelial Tissue-Epithelial

Areolar Tissue- Connective Tissue

White Fibrous/Dense Connective Tissue-Connective Tissue

Adipose Tissue- Connective Tissue

Human Blood-Connective Tissue
Frog Blood-Connective Tissue

Sickle Cell Amenia
Hyaline Cartilage-Connective Tissue

Elastic Cartilage-Connective Tissue

White Fibrocartilage-Connective Tissue

Human Dry Ground Bone-Connective Tissue

Skeletal Muscle-Muscle Tissue

Smooth Muscle-Muscle Tissue

Cardiac Muscle-Muscle Tissue

Cardiac Muscle-Intercalated Discs- Muscle Tissue

Mammal Neuron— Nervous Tissue

Neuron-Rat Brain-Nervous Tissue
